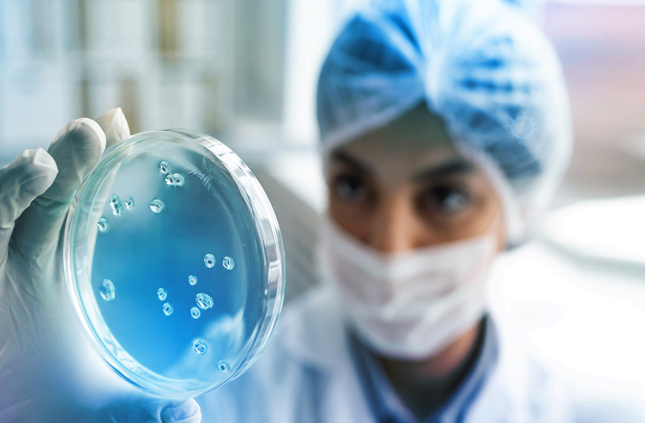

WELCOME
GENETIZ PHARMA
At Genetiz Pharma, we are dedicated to advancing the future of healthcare through innovative pharmaceutical solutions. Our mission is to improve lives globally by developing high-quality medicines that meet the needs of patients, healthcare professionals, and communities. We focus on research, development, and bringing new, cutting-edge treatments to market that address some of the most challenging health conditions.
Innovative Solutions for Better Health
With years of expertise and a deep commitment to scientific innovation, we ensure that every product we deliver is built on a foundation of trust, integrity, and rigorous testing. We take pride in our world-class facilities, state-of-the-art technology, and a team of experts who are passionate about making a difference.
Innovating Health, Transforming Lives
Our Vision
At Genetiz Pharma, our vision is to become a global leader in healthcare innovation, dedicated to improving the lives of millions through groundbreaking therapies and compassionate care. We aim to drive progress in medical research, making advanced, affordable treatments accessible to all. By combining cutting-edge science with a deep commitment to patient well-being, we aspire to shape a healthier, more sustainable future for people around the world.

Our Team
At Genetiz Pharma, our greatest asset is our team. Comprising a diverse group of highly skilled professionals, our team is driven by a shared passion for advancing healthcare and improving patient.

Quality Policy
At Genetiz Pharma, we are committed to providing the highest quality pharmaceutical products and services that meet or exceed the expectations of our customers and regulatory standards.

Manufacturing
At Genetiz Pharma, we pride ourselves on maintaining world-class manufacturing facilities
that adhere to the highest standards of quality and safety.
Why
Genetiz Pharma
Complete evaluation system
Continuous and round the clock control of all production stages from raw materials to final products in quality control laboratories.
Research and Development (R&D)
Responsible for research projects and all processes are based on GMP and WHO rules,


At Genetiz Pharma, our greatest asset is our team. Comprising a diverse group of highly skilled professionals, our team is driven by a shared passion for advancing healthcare and improving patient outcomes.
Quick Link
- HOME
- PRODUCTS
- CAREERS
- CONTACT US
